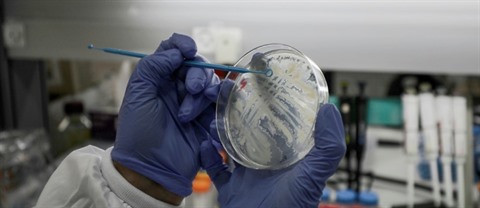

>>COVID-19 : la situation en Indonésie et à Singapour
>>L'ONU, temple du multilatéralisme ébranlé par le coronavirus
>>Les pays s'isolent face à l'avancée inexorable du coronavirus
![]() |
| Berlin affirme vouloir défendre ses laboratoires pharmaceutiques travaillant sur un vaccin contre le coronavirus face aux appétits étrangers. |
L'Allemagne "n'est pas à vendre", a protesté le ministre de l'Économie, Peter Altmaier, sur la chaîne de télévision publique ARD. Et son homologue de l'Intérieur Horst Seehofer a confirmé la véracité des informations publiées le même jour par le quotidien allemand Die Welt sur une tentative du président américain Donald Trump de faire main basse sur le laboratoire allemand en lui proposant une très grosse somme d'argent.
"Je peux juste dire que j'ai entendu aujourd'hui à plusieurs reprises de la part de membres du gouvernement que c'est exact", a-t-il dit lors d'une conférence de presse. Il a annoncé dans la foulée que le sujet serait abordé lundi par le "comité de crise" du gouvernement chargé de piloter la lutte contre l'épidémie de coronavirus, qui a touché à ce jour en Allemagne près de 5.000 personnes et fait 12 morts.
Bras de fer
Au centre du bras de fer : le laboratoire allemand CureVac, situé à Tübingen dans le Sud Ouest du pays. Il est un de ceux dans le monde qui travaillent sur un vaccin contre le Covid-19, en bénéficiant de subventions du gouvernement allemand. Il affirme être "à quelques mois" de pouvoir présenter un projet pour validation clinique.
Selon le journal allemand, le président américain, Donald Trump, essaie d'attirer à coups de millions de dollars des scientifiques allemands travaillant sur ce potentiel vaccin ou d'en obtenir l'exclusivité pour son pays en investissant dans l'entreprise. Ce vaccin serait alors "seulement pour les États-Unis", a affirmé au journal une source proche du gouvernement allemand.
Un représentant gouvernemental américain, interrogé dimanche 15 mars par l’AFP, a estimé que cette affaire était "grandement exagérée". Parlant sous couvert de l'anonymat, il a indiqué que Washington avait parlé à plus de 25 laboratoires pharmaceutiques et assuré que "toute solution qui viendrait à être trouvée serait partagée avec le reste du monde".
![]() |
| La lutte contre le coronavirus est une tâche qui concerne l'humanité toute entière. |
| Photo : AFP/VNA/CVN |
La réalité est toutefois que le Pdg de la société allemande a été personnellement invité par le président américain le 3 mars à la Maison Blanche pour discuter d'"un développement rapide d'un vaccin contre le coronavirus", selon un communiqué de ce laboratoire. Curieusement, la société CureVac a annoncé une semaine plus tard le départ surprise de ce Pdg, sans donner de raison. C'est qu'entretemps la résistance s'est manifestement organisée côté allemand, et notamment au sein de l'entreprise concernée, face aux velléités américaines.
Trump mis en cause
Le ministre allemand de l'Économie s'est ainsi félicité de la "décision formidable" de CureVac de refuser les avances américaines. Un responsable de l'entreprise, Franz-Werner Haas, a confirmé pour sa part l'intérêt de Washington mais a affirmé qu'il n'y avait pas eu d'"offre d'achat". Le président du parti libéral allemand (FDP), Christian Lindner, s'en est lui pris directement à Donald Trump.
"En période électorale tous les moyens sont bons manifestement pour le président américain", soucieux de s'assurer la gloire du premier vaccin, a-t-il dit. "La lutte contre le coronavirus est une tâche qui concerne l'humanité toute entière, il n'y a pas de place pour l'égoïsme", a-t-il ajouté. "Il faut à tout prix empêcher la vente exclusive d'un éventuel vaccin aux États-Unis, il y a des limites au capitalisme", lui a fait écho un responsable du parti social-démocrate, membre de la coalition gouvernementale allemande, Karl Lauterbach.
Berlin a jugé "très important de pouvoir produire des vaccins en Allemagne et en Europe", et prévenu qu'il pouvait mettre son veto à des projets d’investissement dans des entreprises nationales jugées stratégiques. "Le gouvernement a la possibilité d'examiner de près des acquisitions d'entreprises allemandes par des États étrangers, surtout s'il en va des intérêts de sécurité de l'Allemagne et de l'Europe", a averti le ministère de l'Economie.
AFP/VNA/CVN